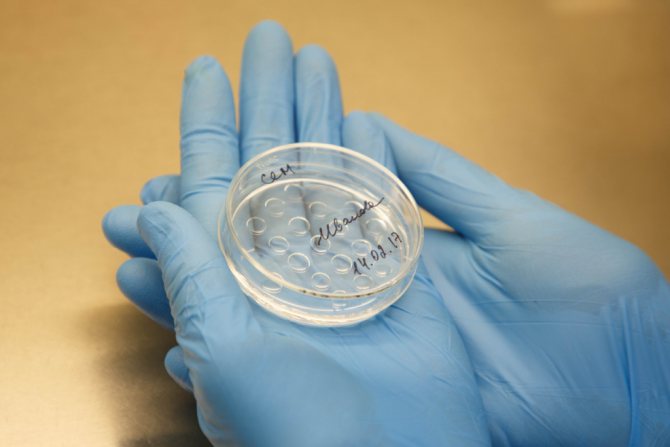
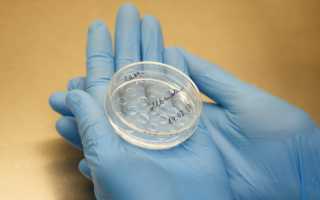

Будущим мамам очень часто бывает не очень непонятно, как рассчитать время начала такой «особенной» беременности, ведь есть определенные отличия от зачатия ребенка обычным путем.
Как определить
При способе зачатия, предусмотренным природой, дату оплодотворения яйцеклетки можно определить, если женщина точно знает день зачатия, а месячные идут регулярно.
Срок беременности после ЭКО имеет схожую картину: женщина точно знает даты оплодотворения яйцеклетки и переноса эмбриона в полость матки (день переноса считают нулевым). Так, как считать срок беременности при ЭКО?
Для определения любой беременности имеют значение первый день последних месячных и шевеления плода. В течение первых двух недель после начала цикла происходит созревание фолликулов в яичнике. У большинства женщин 28-дневный менструальный цикл с овуляцией на 14-15 дни.
В это время может произойти оплодотворение яйцеклетки. Хорошие условия длятся в течение двух суток (с 14 по 16). Если слияние двух клеток произойдет – будущий эмбрион имплантируется в эндометрий, и последующих месячных не будет.
В повседневной жизни супружеские пары не знают точную дату зачатия, могут ее предположить. Большинство из них живут регулярной половой жизнью (один раз в три-пять дней). Возможно, один из них попадет на середину цикла.
Зарождение плода – физиологические аспекты
При экстракорпоральном оплодотворении эмбрион, который отвечает всем признакам физиологического развития, искусственным путем вводится в матку женщины. Для того чтобы увеличить вероятность возникновения беременности, врачи заранее медикаментозно стимулируют овуляцию, продлевая ее на 30 дней.
После этого эмбриону необходимо внедриться в эндометрий и закрепиться в матке. Перед тем, как прижиться в матке, эмбрион проходит несколько стадий развития:
- нулевой день – это день, в который были взяты и оплодотворены яйцеклетки;
- в первый день оценивается успешность слияния мужских половых клеток с женскими;
- в течение второго дня клетки делятся и состоят из 2, 4 или 6 бластомеров;
- на третий день бластомеры делятся и их уже 6 или 8, если набор генов зародыша нежизнеспособен, развитие останавливается;
- с наступление четвертого дня количество клеток увеличивается до 10-16;
- в течение 5-6 дня происходит формирование оболочки эмбриона, ответственной за имплантацию.
При проведении экстракорпорального оплодотворения эмбрион переносится в матку на 3-5 сутки, что говорит о том, что прижиться он должен спустя 3-14 суток.
Вживление плодного яйца может быть ранним (менее 7 дней) и поздним (до 10 дней). Чаще всего наблюдается позднее, связано это необходимостью эмбриона адаптироваться к новым условиям.
На то, когда приживется эмбрион, влияет жизнеспособность зародыша, гормональный фон женщины, состояние эндометрия и психоэмоциональное самочувствие женщины.
Если цикл не регулярный
В этом случае длительность беременности нужно увеличить на каждый день цикла, превышающий 28-30 дней. Если женщину вели по протоколу суперлонг (менструация длительное время подавлялась) – считают сроки беременности при ЭКО со дня переноса эмбриона, прибавляя к нему две недели.
Гинекологи женских консультаций высчитывают дни беременности по специальным календарям, где даты рассчитаны с учетом первого дня последних месячных (ПДПМ), овуляции и первого шевеления плода.
Срок родов определяют по лунному календарю – месяц длится 28 дней. Вынашивание беременности – 280 дней (десять акушерских месяцев или 40 недель). Можно упростить расчет: к ПДПМ прибавить девять календарных месяцев и семь дней.
Еще проще – от даты ПДПМ отнять 3 месяца и прибавить 7 дней. Если считать по овуляции – от дня предполагаемой менструации отсчитать назад 14-16 дней и к этой дате прибавить 273-274 дня.
Первое шевеление плода наступает в 18-20 неделю. Если это произошло в 18 неделю – к дате прибавляют 22 недели и ожидают роды в эти дни, в 20 – прибавляют 5 (акушерских) месяцев — это будет ожидаемый срок.
Эти принципы отсчета заложены в программы различных калькуляторов определения сроков беременности после ЭКО, даты родов после ЭКО, расчета срока беременности по дате переноса эмбрионов. Но все они запрашивают дату первого дня последних месячных.
Ультразвуковое исследование плода позволяет определить до 3-х месяцев эмбриональный срок беременности по КТР (расстоянию от копчика к темени эмбриона). Он меньше акушерского на две недели. Врач по результату измерения в таблице находит соответствующий срок.
Во второй половине беременности измеряются кости плода, окружности груди и животика, размеры внутренних органов. Эти результаты сравнивают с данными в таблице, которая рассчитана уже на акушерский срок.
Как вести себя после процедуры: режим
Естественно, пациенток, которым имплантировали эмбрион, интересуют вопросы, как вести себя после процедуры, чтобы не навредить и приблизить наступление беременности.
Видео: как вести себя после процедуры ЭКО После процедуры женщина может вести себя, как обычно — единственное, не стоит подвергаться тяжёлым физическим упражнениям и прибегать к слишком активному образу жизни.
Однако и постельного режима придерживаться не нужно — специалисты в один голос утверждают, что это никак не повлияет на успешность процедуры, а вот навредить может, поскольку в данном случае органы малого таза будут страдать от недостаточного кровообращения.
Сколько нужно лежать после переноса эмбрионов
После процедуры женщине будет рекомендовано 20-30 минут провести в положении лёжа. Ей будет нужно расслабиться, думать лишь о хорошем и верить в успешную имплантацию.
Питание
В питании для женщины ничего меняться не будет. Не существует ни одного достоверного исследования, которое бы могло доказать, что употребление каких-либо блюд и продуктов вредят либо, наоборот, помогают при зачатии.
Главное, чтобы женщина употребляла лишь свежие продукты, дабы не спровоцировать тяжёлое отравление и кишечные расстройства.
Желательно кушать побольше фруктов и овощей и снизить количество соли для предупреждения задержки жидкости, умерить потребление кофеина. И, конечно же, если хочется, нужно в это время баловать себя любимыми блюдами и десертами.
Прогулки и физическая активность
Как правило, медики не запрещают ни посещение работы, ни перелёты самолётом, ни длительные прогулки, ни утреннюю гимнастику либо несложные занятия йогой, ни домашнюю работу. На успешность прикрепления никак не повлияют ни режимы сна и бодрствования, ни количество отработанных в день часов.
А вот следующие факторы могут негативным образом сказаться на имплантации:
- вредные привычки;
- стрессы, переживания;
- чрезмерные физические нагрузки, в том числе поднятие тяжёлых грузов (тяжелее 2 кг);
- половые контакты;
- вирусные заболевания (поэтому важно избегать контактов с больными людьми и посещения многолюдных мест);
- горячие ванны, в том числе посещение бани и сауны.
Интимная жизнь
Обычно репродуктолог советует воздержаться от половой близости до прикрепления эмбриона к матке и наступления беременности. После закрепления зиготы будут даны другие рекомендации: если всё в порядке и прикрепление к стенкам крепкое, то половая жизнь может быть продолжена в нормальном режиме.
Если же возникнет угроза преждевременного прекращения беременности, то половые акты нужно будет исключить.Вам наверняка будет интересно почитать о том, чем отличаются дети ЭКО от обычных.
Калькулятор
На интернет сайтах существует калькулятор беременности при ЭКО.
Некоторые из них запрашивают уже перечисленные показатели, а также иногда — возраст эмбриона на дату переноса.
- «Календарь беременности после ЭКО» — по дате последних месячных, зачатия (пункции), переноса, рассчитывает срок беременности, соответствующие ему размеры эмбриона или плода по УЗИ, начало декретного отпуска, дату родов.
- «Календарь беременности» – расчет этих параметров ведется с учетом нерегулярного цикла.
- «Рассчитать срок беременности после ЭКО» – по тем же показателям и плюс возраст эмбрионов в день переноса в полость матки, калькулятор беременности после ЭКО высчитает сроки, соответствие возраста эмбриона параметрам УЗИ, дату родов.
Калькулятор ответит на вопрос: как после ЭКО считать недели беременности, но ни один их них не выдаст документ на дородовый отпуск, не сможет наблюдать женщину и плод на протяжении всего срока беременности, с учетом особенностей после экстракорпорального оплодотворения.
Так, может быть, лучше спросить у врача, как определить срок беременности после ЭКО. В природе нет математически точных сроков, все предложенные формулы имеют поправки на разные обстоятельства: экзогенные и эндогенные факторы, влияющие на тонус матки, развитие плода, общее состояние организма женщины, настроение малыша, его желание встречи с миром.
как считать срок беременности после эко крио пятидневок
После самого переноса ближайшие две недели внешне может ничего не происходить, но в матке идут постоянные и непрерывные процессы, которые должны завершиться прикреплением эмбриона к стенке матки, то есть началом беременности. Сам момент прикрепления «имплантацию»; почувствовать невозможно, никакие субъективные признаки на него не указывают вплоть до 14-го дня после переноса, до дня сдачи крови на ХГЧ. Тошнота, головокружение, набухание груди, сонливость, отсутствие предменструальных явлений и т. д. — ничто не является объективным, ни на чем не стоит заострять внимание как на аргументе за или против.
Если вы хотите оценить свои репродуктивные возможности или уже нуждаетесь в лечении – приходите в Клинику МАМА! Мы помогаем!
После пункции и забора яйцеклеток проходит 4–5 дней, и наступает новый этап протокола ЭКО — перенос эмбрионов в полость матки. Сам перенос занимает 2–5 минут, но в день переноса берут также кровь на гормоны прогестерон и эстрадиол — это понадобится в ближайшем будущем. Ведь после переноса в большинстве современных клиник ЭКО проводят поддержку нача
Источник
У нас УЗИ делают на 5-6 неделе после перноса. Чтоб уже можно было сразу увидеть сердечки. Если есть подозрение на ВБ или ЗБ то делают раньше, в зависимости от роста ХГЧ.
А у меня так получилось, что на 12 день после переноса закровила. Врач велела сразу сдеть ХГЧ и сдела УЗИ. ХГЧ был низкий, а вот эмбрион в матке был. Она заверила, что он развиваться не будет и т.п. Я была просто в истерике. Если уж Он там, то что-то можно сделать для его развития? Верить не хотелось.
23ДПП первое УЗИ: 1ПЯ-средний внутренний диаметр-10мм, эмбрион четко не визуализируется, канал шейки матки закрыт, матка в нормотонусе. Заключение:Беременность соответсвует сроку 3 недели 2 дня (от зачатия)
У меня было вчера. на 21 ДПП. увидели ПЯ, но СБ еще не слышно. Приятно, но беспокойство осталось. все равно чего-то не хватает. Даже линейку менять не буду. так как все равно я опять в ожидании УЗи!
Мое первое УЗИ на 19ДПП. В полости матки визуализируется 1ПЯ, СВД-5,5мм округлой формы. ПЯ и ЛЯ с множеством ж/тел. Диагноз — беременность малого срока. Теперь следующее УЗИ на 34ДПП, 25.08.10. Сказали, что должно сердечко биться на сл.УЗИ.
А когда там парочка. то они всегда меньше. И у меня пятидневки. Я вообще сегодня расстроилась. Думала уже эмбриончик будет виден а его еще не видно. Вот и испугалась, плакала.
Привет девочки. Мне делали узи на 30ДПП и уже увидели эмбриончика и серцебиение, а размеров тоже не указано только написоно срок беременности 6-7 акушерских недель. Так что девочки неволнуйтесь раньше времени, сходите на узи еще раз через недельку и там будет все видно. А пока не нервничайте и детишек хватит нервировать.
А когда там парочка. то они всегда меньше. И у меня пятидневки. Я вообще сегодня расстроилась. Думала уже эмбриончик будет виден а его еще не видно. Вот и испугалась, плакала.
Источник
Ты можешь выбрать те разделы, которые хотела бы что бы отображались на этой («Список актуальных тем») страничке. Что бы изменения вступли в силу выбери нуные разделы и закрой окно.
Здравствуйте. Мне 39 лет. Беременность у меня не было. Сделала ЭКО безрезультатно. А сегодня 1-2 дм узи сказали что у меня отсутствует фоликулы. И что всё. Подскажите пожалуйста что мне делать.
Девочки всем привет, такой вопрос кто нибудь делал эко в Казахстане по квоте. сколько времени уходит на все -анализы комиссии, как продвигается очередь.
Вопрос к девочкам,которые уже прошли искуственую инсеминацию. Я делала второй раз подряд ИИ,в этот раз в естественном цикле. Делали спермой донора высокого качества. Но инсеминация проводилась за 2 и 3 дня до овуляции (из за технических причин). Вопрос такой, кто тоже не попал в день овуляции, но бе.
Милые девушки! Может у кого было такое? Это мой первый протокол, подсадили двух 3-х дневочек 25.10, в пятницу 28.10 сделала укол диферелина 0,1 в живот для имплантации. В субботу на 4 дпп (если я правильно считаю дни) в середине дня мне стало плохо, разболелась поясница, голова и слабость появилась.
Привет всем! Опять я вся такая нервная. С начала протокола прошло уже 6 недень. И вот я вся такая еле дотерпевшая прошла УЗИ. И теперь уже 2 дня не сплю. Результат: на 24 ДПП плодное яйцо 13 мм с эмбрионо КТР 3,3 мм (отвечает 5 неделям, желточный мешок 2.6 мм ЧСС 112 уд
Источник
На данной странице собраны наиболее популярные посты и комментарии наших пользователей по теме «перенос после крио». Это поможет вам быстро получить ответ на вопрос, также вы можете принять участие в обсуждении.
Ощущения после крио переноса. Текст длинный, кому не интересно можете не читать☺. Перенос был 25 февраля 2х 5 дневок. Когда тесты еще не заполосатили с 5 дпп болели оба яичника, будто горело и распирало, сомнений в том что все получилось не было)))на 6 дпп тест показал слабую вторую. На 9 дпп уже были яркие 2 полоски. Все это время шел какой-то процесс в животе, была легкая тошнота. На 13 дпп в.
Привет девчонки! Не зная, что делать. Сегодня 4 день после крио переноса. Раздуло низ живота побаливает, и чувство дискомфорта. У кого такое было. Что делать?
Добрый день.Хгч после Крио-переноса двух пятидневок:8дпп-322, 10дпп-865, 14дпп-8560. Это очень много, даже для двойни. Подскажите, почему так может быть, кто сталкивался с подобными ситуациями? Очень волнуюсь узи через 6 дней.
А на УЗИ были? Не хотите полежать на сохранении? Я на 11дпп сдала ХГЧ и репродуктолог отправила полежать недельку на сохранении, так как наша беременность имеет свои особенности проставили попавирин свечи и уколы 10 дней потом на дневном 10 дней полежала дома
Добрый день! Я здесь новенькая, беременность первая, сегодня 13 день после крио переноса эмбриона (ИКСИ), вчера сдала анализы: ХГЧ-823,7Прогестерон-6,5 нг/мл В поддержке были утрожестан 200 мг 2р в д. Дюфастон 1 т 2р в д. Прогинова 3 р в д.Прогестерон очень низкий, у кого так было? Смогли ли Вы его повысить и сохранить беременность? Сейчас добавили ещё одну таблетку Дюфастона и уколы.
Дюфастон не отображается лабораторно. Про утрожестан точно не могу сказать, но, по-моему, тоже. Т.е. вот эти 6.5 — это ваш прогестерон, а есть еще «невидимый». Ну, и уколы тоже д
Источник
Удачное ЭКО — это большая радость для будущих родителей, получивших беременность после прохождения протокола экстракорпорального оплодотворения. Признаки беременности после ЭКО начинают развиваться тогда, когда в кровь поступает хорионический гонадотропин человека. Анализ на его наличие может с точностью сказать, наступила беременность в организме или нет. ХГЧ после ЭКО повышается до 20 недель. Высокое ХГЧ в первые недели развития эмбриона указывает на то, что в матке развивается многоплодная беременность. При проведении искусственного оплодотворения часто происходит развитие двойни, которую сложнее вынашивать. В первом триместре существует риск прерывания таких беременностей. Поэтому в это время проводится УЗИ-контроль, который помогает вовремя обнаружить угрозу прерывания беременности и предотвратить ее. Радость от полученного результата не должна уменьшать контроль за состоянием будущей матери. Нужно вовремя реагировать на все сложности, появляющиеся в связи с вынашиванием двойни и ставить лечащего врача в известность.
Если прошло удачное ЭКО, то после подсадки эмбриона начинается развитие новой жизни в полости матки. 3- или 5-дневные эмбрионы, имплантируемые внутрь матки, прицепившись к ее стенке, начинают свое чудесное превращение в плод. При нормальном их развитии начинается гормональная перестройка в организме женщины. Хорионический гонадотропин человека по своему количеству в крови помогает определить, нормально ли происходит развитие плода в организме женщины.
Имплантация эмбриона — это этап наступления беременности
Яйцеклетка становится эмбрионом в тот момент, когда она сумела прикрепиться к стенкам матки и начала свой рост. Имплантация эмбриона после экстракорпорального оплодотворения происходит на 7 день после проведения процедуры
Источник
Для защиты вашего личного кабинета от несанкционированного доступа на сайте используется подтверждение авторизации с помощью SMS сообщения с кодом. SMS сообщение отправляется на указанный вами номер мобильного телефона.
Указанный вами номер мобильного телефона будет использован только для отправки SMS сообщения с кодом и ни в каких других целях.
При авторизации на сайте используется одноразовый код, отправленный в SMS сообщении на ваш телефон. Укажите свой номер мобильного телефона. Это позволит вам в следующий раз зайти в личный кабинет, чтобы получить ответ врача или продолжить переписку.
После самого переноса ближайшие две недели внешне может ничего не происходить, но в матке идут постоянные и непрерывные процессы, которые должны завершиться прикреплением эмбриона к стенке матки, то есть началом беременности. Сам момент прикрепления «имплантацию»; почувствовать невозможно, никакие субъективные признаки на него не указывают вплоть до 14-го дня после переноса, до дня сдачи крови на ХГЧ. Тошнота, головокружение, набухание груди, сонливость, отсутствие предменструальных явлений и т. д. — ничто не является объективным, ни на чем не стоит заострять внимание как на аргументе за или против.
Если вы хотите оценить свои репродуктивные возможности или уже нуждаетесь в лечении – приходите в Клинику МАМА! Мы помогаем!
После пункции и забора яйцеклеток проходит 4–5 дней, и наступает новый этап протокола ЭКО — перенос эмбрионов в полость матки. Сам перенос занимает 2–5 минут, но в день переноса берут также кровь на гормоны прогестерон и эстрадиол — это понадобится в ближайшем будущем. Ведь после переноса в большинстве современных клиник ЭКО проводят поддержку нача
Источник
Всем привет! Пишу с запозданием.. но немогу не написать.. 18 июня в 21-15 родился наш малыш.. ЕР без стимуляций и просих вмешательств на сроке ровно 39недель с весом 4200 и ростом 54см. 9/10 апгар. Я была в шоке от размеров, т.к. в ЖК убеждали что вс.
После стольких лет ожидания,лечения,операций,пролетов эко, это эко мы решили делать последний раз. Я шла на него опустив руки,как на работу. В итоге- все получилось. Конечно эмбрионы были слабые отставали в развитии,из 8 выжили 2,их и подсадили. Случило.
Собственно вопрос в заголовке. Две недели назад прооперировали, прервали трубную беременность, которая случилась после ЭКО.
Девочки, помогите советом, обратилась ко мне моя знакомая! Эко, пятидневки крио на згт. Поддержка 4 дивигеля и 4 прогиновы, 6 дюфастонов укол прогестерона 2,5. Магний б6. Рост хгч на 9 дпп 384 прогестерон 19,39 нг/мл эстрадиол 614 пг/мл, фибриоген 3,7 норма до 4 и д димер 85 нопма до 243, хгч на 12 дпп 1236 прогестерон 14,71 нг/мл эстрадиол 370,80 пг/мл врач добавляет дивигель 1 пакетик и укол прогестерона и хгч на 15 дпп 2293 прогестерон 21,36 нг/мл эстрадиол 529,50.
вот задалсь таким вопросом — после пункции если собрали не все яйцеклетки — могли какие-то остаться и потом оплодотвориться естественным образом? У меня было ЭКО два года назад, со многими уже тут делилась — на 9 дпп — 3,6 хгч, на 14 дпп — 89, потом нормальный рост и роды. Пятидневка. После пункции несколько раз был секс с мужем. До сих пор почему то думаю а вдруг это естественное зачатие? Что думаете?
Привет, девочки! Получила результат АМГ — 0.19!:( Ездили с мужем на приём к репродуктологу вчера. В голове сумбур, не знаю, за что хвататься. Знаю, что я не первая, простите, что много текста. Я даже не могу сказать, что прошу совета, ибо не знаю, в чём. Скорее так, поплакаться и попросить поддержки. Скопировала
Перенос эмбриона в полость матки
Как правило, репродуктологи, целью которых является максимальное повышение шансов на имплантацию зародышей в стенку матки с последующим наступлением беременности и предупреждение многоплодия, осуществляют перенос 1–2 эмбрионов. Данная процедура осуществляется на гинекологическом кресле в условиях оперблока под контролем ультразвукового аппарата. Сначала пациентка принимает седативный лекарственный препарат. После того, как он подействует, приступают непосредственно к процедуре.
Тонкий пластмассовый катетер надевается на шприц емкостью 1 мл, затем в него набираются эмбрионы вместе со средой для культивации и 2 пузырьками кислорода. Цервикальный канал шейки матки очищается от слизи, только после этого устройство вводится в маточную полость. Затем его приближают ко дну и медленно выпускают содержимое шприца на эндометрий. Под конец процедуры проверяют, не остались ли на катетере зародыши. Ниже представлено фото и видео данного процесса.
Что происходит после имплантации?
По прошествии 2 недель с переноса эмбриона проводится тест на определение беременности. На 21-й день пациентке назначается УЗИ для окончательного подтверждения успешного зачатия. При удачном течении гестации развитие и рождение плода происходит так же, как и при естественном оплодотворении. С момента зачатия до родов проходит 9 месяцев, при этом срок определяется по акушерскому календарю, в каждом месяце которого 28 дней.
На 13–18 день гестации на оболочке эмбриона формируются хориальные ворсинки – основа плодного яйца, хориона и будущей пуповины. В этот период происходит активное деление клеток, образование примитивной системы кровообращения, формирование амниона.
В последующие 3 недели у зародыша начинает биться сердечко. По прошествии 20–22 дней с момента наступления беременности у эмбриона формируются зачатки головного и спинного мозга, кишечника. Через 4 дня начинают образовываться глаза, уши, нос, рот. По окончании первых двух акушерских месяцев зародыш становится плодом.
Через 18–28 дней с момента наступления беременности образуется нервная трубка будущего ребенка. На двенадцатой неделе гестации плод уже может глотать, сосать пальчики, двигаться. На 40-й неделе происходит постепенное старение плаценты, запускается естественный процесс родов. Для отслеживания состояния ребенка и характера течения беременности необходимо делать УЗИ примерно на 12, 20 и 32 неделе гестации.
Возможные причины остановки развития эмбрионов
В 15% случаев после ЭКО развитие эмбрионов прекращается в процессе митотического деления еще в фазе 2–4 клеток. Некоторые из них перестают развиваться сразу по завершении оплодотворения. Более чем у половины замерших зародышей выявляются генетические аномалии. Наряду с этим существуют и другие факторы, провоцирующие данное патологическое явление:
- неблагоприятные условия инкубации,
- хромосомные дефекты,
- нарушение активации генома зародыша,
- аномалии микроскопических мембранных органоидов, обеспечивающих клетку энергией.
https://youtu.be/Y1on0PT1bVw
Как происходит забор яйцеклеток и отбор спермы
Почти сразу после начала менструального цикла для стимуляции созревания нескольких яйцеклеток в яичниках пациентке назначаются гонадотропины (если речь не идет о протоколе в естественном цикле). Необходимость получения их в большом количестве объясняется тем, что не все они оплодотворятся или впоследствии правильно разовьются. При достижении фолликулами оптимальных параметров и полного созревания яйцеклеток для стимуляции овуляции женщине вводится хорионический гонадотропин.
По прошествии 36–48-часового интервала созревшие женские половые клетки извлекают из яичников. Забор яйцеклеток осуществляется под общим или местным обезболиванием (в зависимости от состояния пациентки). Под контролем УЗИ тонкой иглой производится пункция яичника через верхнюю стенку влагалища. В результате прокола каждого фолликула получают все ооциты. Данная процедура длится не более 20 минут. При невозможности получения яйцеклеток или при неудовлетворительном их качестве применяют донорские половые клетки.
В день забора яйцеклеток осуществляется и забор спермы, получаемой путем мастурбации. Однако при наличии определенных патологий прибегают к биопсии яичка или хирургическому вмешательству, позволяющему извлечь биологический материал непосредственно из яичек.